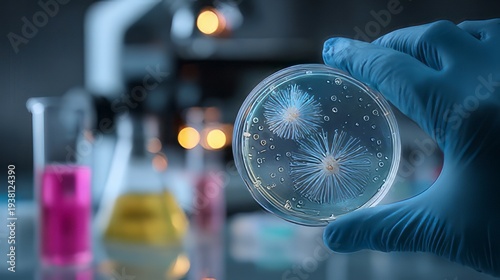

Download sample
File Details
Published: 2026-03-06 13:05:48.475480 Category: Hobbies and Leisure Type: Illustration Model release: NoShare
Scientific laboratory setting where a researcher is examining cultured Petri dish. Scientist hand wearing a blue protective glove is holding a Petri dish containing cell cultures or microorganisms.
Contributor: Taiwo
ID : 1938124390
